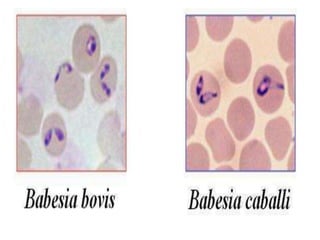

Babesiosis is a tick-borne disease caused by Babesia spp., primarily affecting red blood cells in cattle and causing symptoms like high fever, loss of appetite, and coffee-colored urine. The disease is prevalent globally, particularly in humid and tropical areas, and while it can cause severe illness and sporadic outbreaks, it is treatable with various medications if administered early. Control measures include treatment, vaccination, and targeted tick control, although challenges remain due to the complexity of effective tick management.